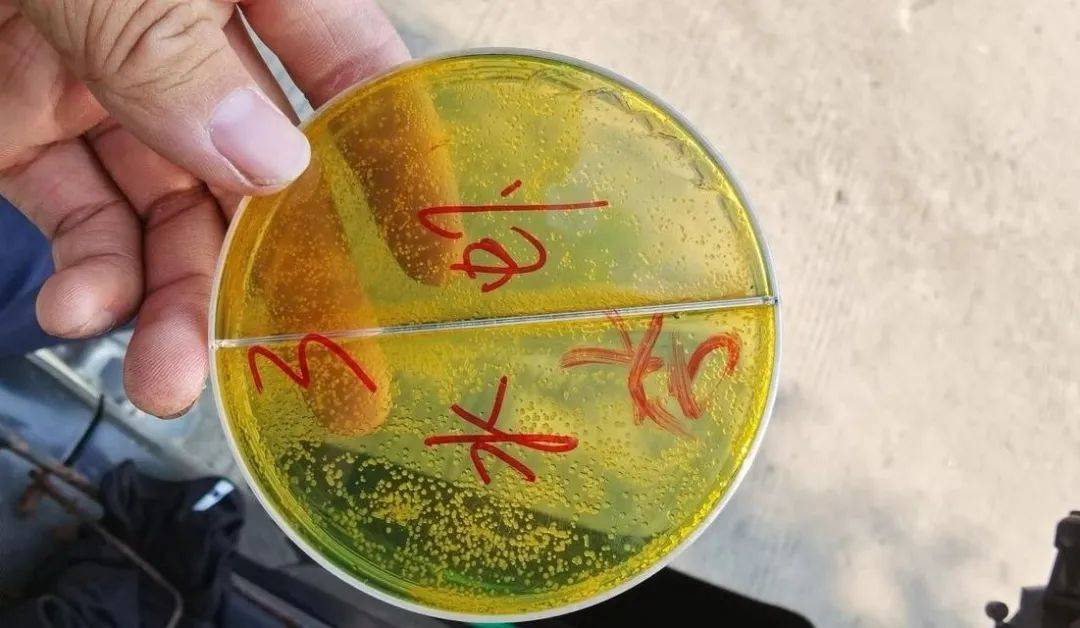
还靠消杀来处理弧菌?用这个方法,反而防治更轻松了_消毒_控制_池塘

泥皮菌

梅州这种珍贵野味,只有下雨天才出现,很多人都没吃过
图片尺寸655x435
这是什么菌呢?
图片尺寸500x667
这是什么菌
图片尺寸780x1040
谁能告诉我这是什么菌类啊?偶然间看到的,请懂的告诉我,谢谢.
图片尺寸4095x3071
竹荪蛋怎么清洗 - 菌贝网-www.junbei.com
图片尺寸800x597
其实还有这些哦
图片尺寸640x358
其实还有这些哦
图片尺寸600x449
菌类
图片尺寸670x446
请问这是什么菌(蘑菇)?能吃吗?有人在山上卖,说是野摘的.
图片尺寸3120x4160
这个菌子比肉好吃,食材珍贵难得,吃到不容易,被誉为食用菌皇后
图片尺寸620x489
团购专享 | 来自香格里拉普达措国家公园产区的出口级松茸
图片尺寸640x853
9.3日工作汇报
图片尺寸1600x1200
青苔泥皮一扫光分解泥皮油膜鱼虾蟹塘小龙虾水质调节水产养殖em菌
图片尺寸960x960
看不良水质是如何形成的?居然有这么多危害!
图片尺寸636x373
处理方案:1,入冬前使用1次浓缩芽孢杆菌2亩/袋,分解水体有机质,减少有
图片尺寸669x893
小龙虾养殖注意这些细节征兆轻松养殖稳赚钱
图片尺寸640x480
野菜_南雄_腊肉
图片尺寸640x470
还靠消杀来处理弧菌?用这个方法,反而防治更轻松了_消毒_控制_池塘
图片尺寸1080x628
余波老师作品欣赏
图片尺寸600x800
全熟羊头肉4斤装 新鲜冷冻整只羊脸肉羊下水羊杂熟食去骨现煮包邮
图片尺寸800x800